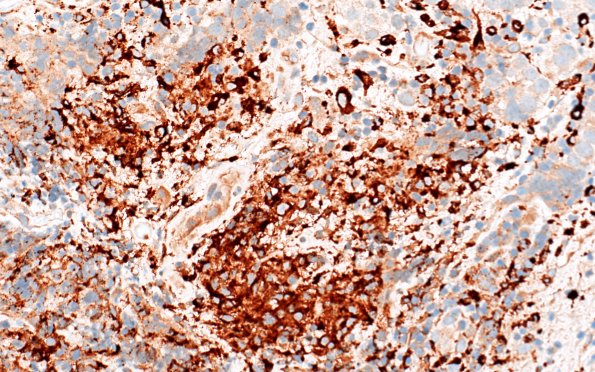
18G3 Germinoma pineal (Case 18) CD68 40X

Table of Contents
Washington University Experience | NEOPLASMS (NON-GLIAL NON-NEURONAL) | Germ Cell Neoplasm - Germinoma | 18G3 Germinoma pineal (Case 18) CD68 40X
CD68 immunoreactivity highlights the epithelioid cells composing the granulomas. (CD68 IHC)